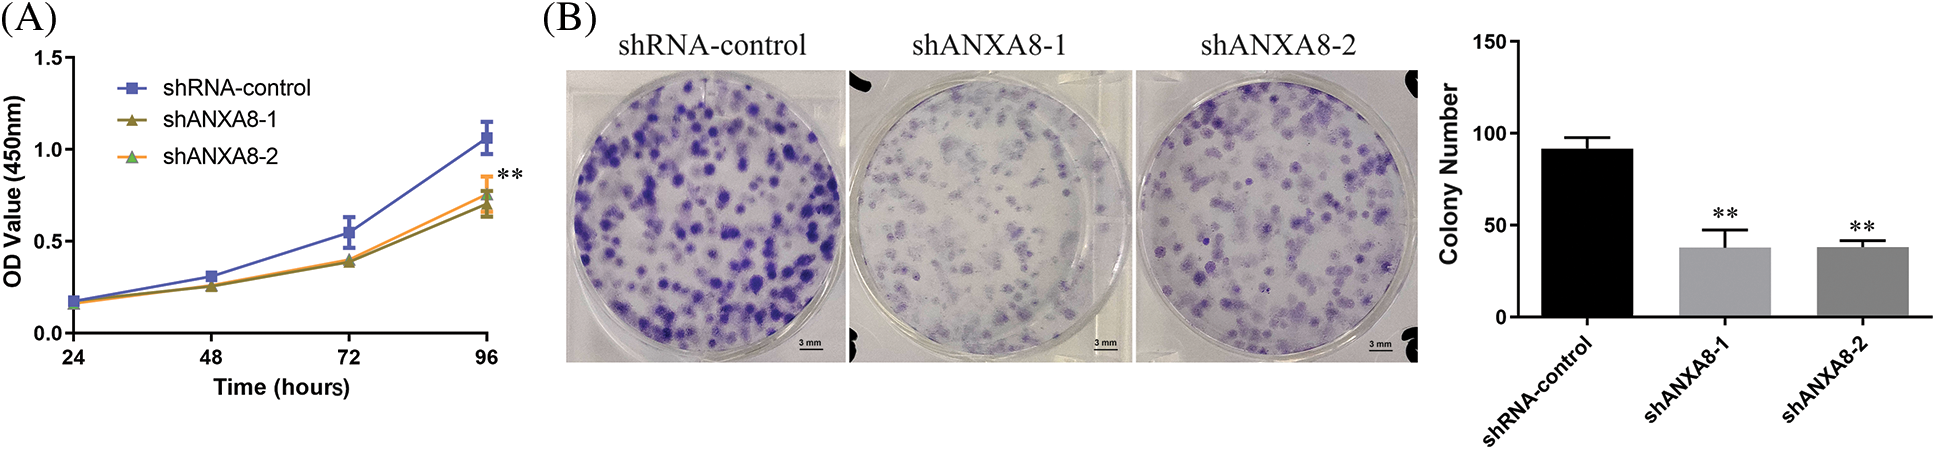
images

Open Access
ARTICLE
Knockdown Annexin A8 inhibits the proliferation and invasion of cervical cancer cells
1 Department of Gynecology and Obstetrics, The Second Affiliated Hospital of Soochow University, Suzhou, 215004, China
2 Department of Gynecology Oncology, Affiliated Tumor Hospital of Nantong University, Nantong, 226300, China
* Corresponding Author: WEIPEI ZHU. Email:
BIOCELL 2023, 47(12), 2697-2708. https://doi.org/10.32604/biocell.2023.044314
Received 27 July 2023; Accepted 06 September 2023; Issue published 27 December 2023
Abstract
Background: This study aimed to explore the expression, function, and molecular mechanism of ANXA8, the gene for annexin 8, in cervical cancer. Methods: The gene expression of the ANX family members in cervical cancer tissues was classified via The Cancer Genome Atlas (TCGA) database. The expression of ANXA8 in paracancerous tissues, cervical cancer tissues, and cell lines was identified by fluorescence quantitative polymerase chain reaction (PCR) and immunohistochemistry. The effects of ANXA8 knockdown on the cellular growth and cell invasion of cervical cancer were examined by MTT, clone-formation assay, scratch test, and Transwell assay. The effect of ANXA8 knockdown on the proliferative potency of cervical cancer cells was assessed through an in vivo nude-mouse tumor-formation test. The gene expression levels of Ki-67 and ANXA8 in tumor-bearing tissues were measured through Immunohistochemical analysis. Results: TCGA data analysis and fluorescence quantitative PCR exhibited significantly increased expression of ANXA8 in cervical cancer tissues. Further examination exhibited that ANXA8 was expressed exceedingly in cervical cancer tissue, and it was associated with lymph node metastasis, FIGO stage, degree of differentiation, and infiltration depth of cancer patients. Cell-function assays revealed that knocking down ANXA8 may substantially suppress the propagation, colony formation, invasion, and migration of cervical cancer cells. In vivo experiments demonstrated that ANXA8 knockdown had a substantial inhibitory effect on the propagation of cervical cancer cells in nude mice and inhibited the expression of Ki-67. Conclusion: ANXA8 is specifically and significantly upregulated within cervical cancer tissues. The knockdown of this gene showed remarkable outcomes, as evidenced by the substantial inhibition of cervical cancer cell proliferation in in vitro and in vivo experimentations. Therefore, ANXA8 is a potential target or a marker that can serve as a therapeutic or diagnostic tool for cervical cancer.Keywords
Cervical cancer is a widely recognized malignant tumor affecting the female reproductive tract, and its primary histological types, squamous cell carcinoma and adenocarcinoma pose significant threats to women’s health (Rahangdale et al., 2022; Miller and Pinsky, 2022). According to the recently published 2022 cancer statistics report from esteemed cancer centers in both China and the United States, cervical cancer has emerged as the second most prevalent malignancy among females in China, following breast cancer. Moreover, the incidence rate of cervical cancer is displaying a trend toward affecting younger individuals, which seriously threatens women’s health (Xia et al., 2022). The implementation of cervical cytology screening has led to the identification and prompt management of cervical cancer and precancerous lesions at an early stage, thereby resulting in a substantial decline in the morbidity and mortality of cervical cancer (Huang et al., 2022). However, advanced or recurrent cervical cancer still has no cure (Bogani et al., 2022; Johnson et al., 2019).
The treatment for cervical cancer mostly depends on resection, but the 5-year survival rate of a patient with advanced cervical cancer remains unsatisfactory. Thus, understanding the molecular mechanism underlying the incidence and expansion of cervical cancer will be beneficial for identifying biomarkers that can predicting and diagnose cervical cancer. In particular, providing patients with the best treatment options or disease monitoring for early judgment is important and urgent.
Annexins (ANXs) belong to Ca2+ receptor proteins, and their existence sites are connected with the plasma membrane and other sites where cells sense external stimuli. They are closely related to phospholipid metabolism and protein phosphorylation, so they may play an essential role in intracellular information transfer (Méndez-Barbero et al., 2021; Popa et al., 2018). Mammals have 12 ANX species, namely, ANXA1, ANXA2, ANXA3, ANXA4, ANXA5, ANXA6, ANXA7, ANXA8, ANXA9, ANXA10, ANXA11, and ANXA13. They are extensive under the plasma membrane, near the Ca2+ storage organelles, and in the nucleus or in the extracellular matrix (ECM) (Schloer et al., 2018; Enrich et al., 2017). ANXs reportedly have a key role in the occurrence and development of tumors, such as mediating cell adhesion, cell proliferation, invasion, and differentiation. Abnormal function of these signaling proteins may cause tumor cells to abnormally regulate proliferation, causing protein deletion or structural changes, and may thus increase the metastatic potential of tumors (Lauritzen et al., 2015).
For example, ANXA1, as an earlier discovered member of this family, is also one of the earliest and most studied ANXs. ANXA1 is abnormally expressed in many tumor tissues, such as lung adenocarcinoma, breast cancer, liver cancer, pancreatic cancer, etc., (Guo et al., 2013; Han et al., 2020; Araújo et al., 2021). ANXA2 is extensively distributed in the cellular nuclei, cytoplasm, and extracellular regions of the cell surface and is closely associated with tumor development and metastasis. For instance, ANXA2 is significantly upregulated in serum samples of lung cancer patients and well-differentiated malignant glioma (Christensen et al., 2018). ANXA8 is a Ca2+-dependent phospholipid-binding protein that belongs to the ANX family. Numerous clinical and fundamental investigations have demonstrated the contribution of ANXA8 in regulating several physiological processes within the human body (Oka et al., 2016; Jiang et al., 2019). Knockdown of ANXA8 leads to a notable inhibition of human umbilical vein endothelial cell activation provoked by vascular endothelial growth factor (VEGF-A). The silencing of ANXA8 also inhibits the migration and adhesion of β1 integrin binding to the ECM. The expression of ECM protein, ANXA, affects the complex formation of VEGFR2/CD63/β1 integrin, causing the overactivation of the VEGF-A signaling pathway and interfering in angiogenesis driven with VEGF-A (Heitzig et al., 2017). In lung cancer, ANXA8 overexpression prompts the propagation and migration of A549 cells. The expression of cyclin E1 also increases in A549 cells transfected with ANXA8. Knocking down ANXA8 by RNA interference can reduce the viability of A549 cells in vitro and inhibit its migration. Molecular-mechanism research shows that ANXA8 activates the singling pathway of the EGFR/mTOR/Akt complex (Zhou et al., 2021). The above experimental findings show that ANXA8 is also an important functional molecule in a class of cells, and can significantly regulate various physiological functions of tumor cells. However, the possible role of ANXA8 and its molecular mechanism in the cervical canal has not yet been reported. Therefore, the present study explored the expression, function, and molecular mechanism of ANXA8 in cervical cancer.
Collection of clinical samples
The Ethics Committee of the Affiliated Tumor Hospital of Nantong University provided approval for this study (No. 2023-A09). The patients or their families signed the informed consent. Tumor tissues from 30 patients with cervical cancer who underwent surgical treatment from January 2022 to December 2022, along with 11 paired adjacent normal tissues, were collected. A total of 110 cases of cervical cancer tissue chips were purchased from (Shanghai Xinchao Biotechnology Co., Ltd., Shanghai, China).
The expression of ANX family members ANXA1–11 and ANXA13 in cervical cancer was analyzed through the TCGA database (http://gepia.cancer-pku.cn/detail.php).
A human immortalized cervical squamous cell line, represented as Ect1/E6E7, along with five cell lines of cervical cancer (C33A, CasKi, HeLa, SiHa, and C4I), were procured from the (Shanghai Institute of Biological Sciences, Shanghai, China). RPMI1640 culture medium (Ect1/E6E7, CasKi, HeLa) and Dulbecco’s Modified Eagle’s Medium (DMEM) (C33A, SiHa, and C4I) supplemented with fetal bovine serum (10% FBS) (Sigma–Aldrich, St. Louis, MO, USA), 100 U/mL penicillin, and 100 µg/mL streptomycin were used to culture cells at 37°C in an incubator containing 5% CO2.
Fluorescence quantitative polymerase chain reaction (PCR)
Trizol solution (Invitrogen, USA) was used to isolate total RNA from cells and tissues. After isolation, a Nanodrop2000 spectrophotometer was used to measure the purity and concentration of total RNA. The expression of ANXA1, ANXA2, ANXA3, and ANXA8 was analyzed using Applied Biosystems 7500 Fast. The relative quantification of each gene was conducted using the double standard-curve method. The relative expression levels of each gene were determined via the 2−ΔΔCt method, which involved calculating the difference in Ct values between the target gene and the internal reference gene (ΔCt). Then, the difference in ΔCt values was calculated between the transfection and control groups (ΔΔCt) (Zhou et al., 2021). ANXA8 forward primer: 5′-GGAATTCCTCTGGATAAGGCGCCAGTG-3′; downstream primer: 5′-GCTCTAGATTTCTGAGCCTTCAGGGGTCG-3′.
Immunohistochemical staining (IHC)
IHC staining assay was conducted as described previously (Oka et al., 2016). Images were analyzed by two independent pathologists. The percentage of positive cells and staining intensity of the nucleus under the microscope were determined. The final scores were divided into low expression (0-5) and high expression (>5). Rabbit anti-ANXA8 (1:100, Abcam, Cambridge, UK) and anti-Ki67 (1:150, Abcam, Cambridge, UK) were used. Images were obtained using a fluorescence microscope (Olympus, Tokyo, Japan).
The subcultured cells were then incubated in a 5% CO2 incubator with a maintained temperature of 37°C. The medium was replaced with a fresh one every 1 to 2 days, and the interference sequence targeting ANXA8 was synthesized and packaged with lentivirus by Shanghai Sangon. The cells were passaged on reaching 90% confluence. Cells were allowed to seed and grow into six-well plates and incubated for 24 h. Upon reaching 70% confluence, the cells were transfected with the interference construct following the instructions of Lipofectamine (Thermo Fisher Scientific, Waltham, USA). Following transfection, the culture was maintained for 48 h, during which the cells were utilized for subsequent experimental procedures.
Cells in the logarithmic phase were cultured on a 96-well plate and transfected when the cell-growth reached 50% confluence. Three duplicate wells were made for each group, and the cells were transfected and cultured for different durations: 24, 48, 72, and 96 h. After adding 20 μL of MTT solution (0.5 mg/mL, Sigma-Aldrich, Missouri, USA) to each well of cells, the plate was incubated for 4 h at 37°C and then taken out. The supernatant was removed, 150 μL of dimethyl sulfoxide was added, mixed well, and allowed to react for 10 min. Optical density was measured using a microplate reader at 450 nm wavelength (Ruan and Jiang, 2022).
In accordance with standard laboratory practices, cells were trypsinized, followed by centrifugation to separate the supernatant from the cell pellet. The supernatant was subsequently discarded, and the cell density was adjusted to a concentration of 1000 cells/mL. The prepared cell suspension was evenly cultured on a six-well plate, shaken evenly from side to side, and incubated. For culturing, the medium was replaced with a fresh one every 3 days. The number of cell colonies was observed after 14 days, fixed with 4% paraformaldehyde, washed thrice with PBS buffer, and stained using 1% crystal violet for 10 min to take pictures and count (Ruan and Jiang, 2022).
The transfected cervical cancer cells were digested with trypsin, and cell pellets were collected after discarding the supernatant. Cell density (3 × 105/well) was adjusted and planted onto a six-well plate, shaken evenly from side to side, placed in an incubator for growth, and passaged when the cell fusion reached 90%. A scratch test was performed using a 200 μL pipette tip, and photos were taken. This time was recorded as 0 h and cell migration was observed after 36 h (Bai et al., 2022).
Transwell detection of cell migration and invasion
To simulate in vivo conditions, a layer of matrigel was uniformly applied onto the upper chamber of each Transwell. The cell suspension in the logarithmic growth phase was collected and washed with PBS buffer three times. The density of the cell suspension was adjusted to 2 × 105/mL, and 20 μL of cell suspension was introduced to the upper chamber of the Transwell. To the lower chamber of the Transwell, 500 μL of complete DMEM was added and incubated at 37°C overnight, fixed with formaldehyde, and stained with crystal violet for analysis and observed under an optical microscope. Cells transferred to the back side of the Transwell chamber were randomly counted in five fields of view under 200× magnification. The experiment was performed three times, and the average value was taken (Luan et al., 2021).
Formation of subcutaneous tumor in nude mice
Female BALB/c nu/nu thymus-deficient nude mice were obtained from the Shanghai Experimental Animal Center of the Chinese Academy of Sciences (n = 18, weighing about 18–20 g, aged 4–6 weeks). Mice were randomly divided into three groups, with six mice in each group. Each group had six nude mice, that were raised in a specific pathogen-free-grade animal experiment center and reared in separate cages. The animal room was subjected to alternating light and dark conditions while maintaining constant levels of humidity and temperature. Following the initial period of observation and feeding, subsequent experiments were conducted over a duration of one week. SiHa cells were transfected with three distinct groups: the blank control group (shRNA-control) and two groups with ANXA8-targeting interference sequences (shANXA8-1 and shANXA8-2). They were then transformed into a homogeneous single-cell suspension, and the cell dose was adjusted to 1 × 107 cells/mL. The bare back was disinfected with povidone iodine, and a sterile syringe was used to inject cell suspension (100 μL) into the dorsal region of nude mice. The mice were allowed to grow for 30 days according to previous normal conditions, and their tumor formation, food intake, drinking water, and activity status were observed every 2 days. The dimensions of tumor-bearing mice were measured with a vernier caliper, and measure the long neck of the transplanted tumor and the short neck were measured. We calculated the transplanted tumor mass volume according to the formula V = [(a * b * b)/2], where V is the volume of the transplanted tumor mass using two parameters, namely, the long (a) and short (b) diameters. These measurements are crucial in determining the overall size and shape of the tumor mass. The weights of the rats were recorded and their volumes were determined. After completion of the experimental procedure, the mice were euthanized by cervical dislocation. The tumor-bearing tissue was preserved in two forms: (1) in liquid nitrogen for fluorescence quantitative PCR, (2) in 4% formaldehyde for IHC staining. All the experiments complied with the guidelines of the Institutional Animal Care and Use Committee on Animal Care and Use.
This study was approved by the Institutional Animal Ethics Committee of Nantong University Animal Experimental Center (No. 20230220-618).
SPSS version 19.0 was utilized to quantify all experimental data, which were expressed as the mean ± standard deviation. Comparison between various groups of measurement data obeying the normal distribution was performed by student t-test or ANOVA. A nonparametric rank sum test (Mann-Whitney U test) was used to analyze measurement data that deviated from a normal distribution. The count data were used for statistical analysis using the chi-square test. The difference was considered statistically significant when the p-value was less than 0.05 (p < 0.05).
Expression levels of the ANX family members in cervical cancer tissues
The expression of ANX family members ANXA1–11 and ANXA13 in cervical cancer was analyzed through the TCGA database (http://gepia.cancer-pku.cn/detail.php). Results showed that the expression levels of seven genes, including ANXA4, ANXA5, ANXA7, ANXA9, ANXA10, ANXA11, and ANXA13 (Suppl. Fig. S1), exhibited no significant changes compared with adjacent tissues (normal tissues). The expression levels of one gene, ANXA6, was low in tissues (Suppl. Fig. S2). Four genes, namely, ANXA1, ANXA2, ANXA3, and ANXA8, had expression levels that significantly increased in cervical cancer (Fig. 1).

Figure 1: Compared with normal tissue (N), genes with significantly increased expression levels in cervical cancer (T) tissue, *p < 0.05. CESC, cervical squamous cell carcinoma, and endocervical adenocarcinoma; T, tumor; N, normal.
To verify the above analysis results, the expression of ANXA1, ANXA2, ANXA3, and ANXA8 in cervical cancer tissues was examined by fluorescence quantitative PCR after in 30 cases of cervical cancer tissues and 11 cases of normal tissues collected earlier. Compared with normal tissues, ANXA1, ANXA2, ANXA3, and ANXA8 were significantly expressed in cervical cancer tissues (Fig. 2), consistent with the published results in previous TCGA data. Among them, the expression difference of ANXA8 in normal tissue and cervical cancer tissue was the most significant; that is, the p-value was the smallest. Based on these findings, we speculated a possible crucial role of ANXA8 in physiological regulatory function during the development of cervical cancer.

Figure 2: Expression of ANXA1, ANXA2, ANXA3, and ANXA8 in cervical cancer tissues detected by fluorescence quantitative polymerase chain reaction. Student t-test was used for comparison between groups.
Elevated expression of ANXA8 in cervical cancer tissues
For further investigation of ANXA8 expression in cervical cancer tissues, 110 pathological sections with survival period and follow-up treatment were collected from the pathology department, including 25 cases with paracancerous tissues. ANXA8 expression was examined by IHC. According to the antibody specification, ANXA8 was primarily confined in the cytoplasm, and the staining results in cervical cancer revealed that it was consistent with the specification, that is, in cervical cancer tissues. ANXA8 stained darker and was primarily located in the cytoplasm (Fig. 3A), and lighter in normal tissues and had a lower expression level. These findings were consistent with those of further scoring of IHC staining, indicating that ANXA8 was remarkably expressed in cervical cancer tissues (Fig. 3B).

Figure 3: Immunohistochemical examinations of ANXA8 expression in cervical cancer tissues. (A) Representative images of IHC staining with anti-ANXA8 antibody from cervical cancer (CC) tissues and adjacent cervical epithelial tissues in a human CC tissue microarray. The scale bar is 100 μm. (B) Scores of IHC staining are presented. **p < 0.01. Student t-test was used for comparison between groups.
According to the IHC scoring results, a score of ≥5 meant high expression, and a score of <5 meant low expression. A total of 110 cervical cancer patients were thus distributed into high- and low-expression groups. The association between the high/low expression of ANXA8 and the clinical case characteristics of cervical cancer patients was analyzed. The findings revealed that ANXA8 expression was associated with lymph-node metastasis, Federation Internationale de Gynecologie et d'Obstetrique (FIGO) stage, differentiation degree, and invasion depth of the patients (Table 1).

Elevated expression of ANXA8 in cervical cancer cells
ANXA8 had remarkably increased expression in cervical cancer tissues. To further investigate ANXA8 expression in the cervical cancer cell line, a human immortalized cervical squamous cell line (Ect1/E6E7) and five cervical cancer cell lines were first detected by fluorescence quantitative PCR. For the cell line (C33A, CasKi, HeLa, SiHa, and C4I) epithelial cells, the outcomes exhibited that compared with human immortalized cervical squamous cells, ANXA8 was extremely upregulated in cervical cancer cell lines, the expression was higher in SiHa and C4I and lower in C33A and CasKi (Fig. 4A). Therefore, SiHa cells were used for subsequent transfection and cell experiments. To further verify ANXA8 function in cervical cancer cells, two ANXA8-targeting interference sequences (shANXA8-1 and shANXA8-2) and a blank control (shRNA-control and random sequence) were constructed by lentivirus. The findings exhibited that compared with the blank control group (shRNA-control), the transfection of ANXA8-targeting interference sequences (shANXA8-1 and shANXA8-2) may significantly knocked-down the expression of ANXA8 mRNA in cells (Fig. 4B). Among them, shANXA8-1 had higher knockdown efficiency than shANXA8-2.

Figure 4: ANXA8 was remarkably upregulated in cervical cancer cell lines. (A) Real-time quantitative polymerase chain reaction (PCR) detection of ANXA8 expression in cervical cancer cell lines. (B) Real-time quantitative PCR detection of ANXA8 mRNA expression in cervical cancer cells (SiHa) after transfection of knockdown ANXA8 vector case. *p < 0.05, **p < 0.01. Student t-test was used for comparison between groups.
Knockdown of ANXA8 reduced the propagation and invasion of cervical cancer cells
MTT was utilized to observed the effect of ANXA8 knockdown on the capability of proliferation of cervical cancer cells. The findings showed that in contrast with the blank control group (shRNA-control), after transfection of ANXA-targeting interference sequences (shANXA8-1 and shANXA8-2) at 72 and 96 h, markedly reduced the propagation of cervical cancer cells (Fig. 5A). A clone-formation experiment was conducted, and results revealed that in contrast with the blank control group (shRNA-control), the transfection targeting ANXA8 (shANXA8-1 and shANXA8-2) interference sequences could significantly inhibit cervical cancer cells at 72 and 96 h The number of colonies formed (Fig. 5B). These findings indicated the involvement of ANXA8 in regulating the proliferation of cervical cancer cells.
Figure 5: ANXA8 knocking-down effect on the propagation of cervical cancer cells (SiHa). (A) The effect of knocking down ANXA8 on the propagation ability of cervical cancer cells was examined by CCK-8. (B) The effect of knocking down ANXA8 on the proliferation ability of cervical cancer cells was observed by clone formation. **p < 0.01. Student t-test was used for comparison between groups.
Further scratch experiments exhibited that in contrast with the blank control group (shRNA-control), the ability of uterine cancer cell migration can be considerably reduced at 36 h after transfection of shANXA8-1 and shANXA8-2 interference sequences (Fig. 6A). Transwell experiments results further verified the effect of ANXA8 on cervical cancer cell migration and invasion. The number of cells migrating and invading from the upper chamber of the Transwell to the lower layer was significantly reduced after the interference sequence (Fig. 6B).

Figure 6: Effect of knocking down ANXA8 on the migration and invasion ability of cervical cancer cells (SiHa). (A) Scratch test to detect the effect of knocking down ANXA8 on the proliferation of cervical cancer cells (scale bar = 100 μm), (B) Transwell assay to detect the effect of knocking down ANXA8 on cell migration (Migration) and invasion (Invasion) (scale bar = 100 μm). **p < 0.01. Student t-test was used for comparison between groups.
In vivo experiments to detect the effect of knocking down ANXA8 on the proliferation ability of cervical cancer cells in vivo
Different groups of cervical cancer cells with ANXA8 knockdown were subcutaneously inoculated with cervical cancer cells for 30 days. The subcutaneous tumor-bearing tissues of nude mice were removed. After 30 days, the morphology of different groups of tumor-bearing tissues formed was observed (Fig. 7A). Compared with the blank control group (shRNA-control), the cervical cancer cells transfected with shANXA8-1 and shANXA8-2 interfering sequences were significantly smaller in the subcutaneous tumor-bearing tissue volume of nude mice (Fig. 7B). Further weighing of the tumor-bearing tissue, revealed that the weight of the tumor-bearing tissue after ANXA8 knockdown was also significantly less than that of the blank control group (Fig. 7C). Then, the total mRNA in tumor-bearing tissues was extracted. Quantitative PCR analysis showed that compared with the blank control group (shRNA-control), ANXA8 expression in tumor-bearing tissues after knocking down ANXA8 was significantly reduced (Fig. 7D). Subsequently, IHC analysis on the tumor-bearing tissues showed that compared with the blank control group (shRNA-control), Ki-67 and ANXA8 expression levels in the tumor-bearing tissues after knocking down ANXA8 were significantly reduced (Fig. 8). The above findings proved that knocking down ANXA8 can significantly inhibit the proliferation ability of cervical cancer cells in vivo.

Figure 7: In vivo experiments to detect the effect of knocking down ANXA8 on the proliferation ability of cervical cancer cells (SiHa) in vivo. (A) Morphology of different groups of tumor-bearing tissues formed after subcutaneous inoculation of cervical cancer cells for 30 days. (B) Volume statistics of different groups of tumor-bearing tissues. (C) Statistical analysis of weight of tumor-bearing tissues. (D) Real-time quantitative PCR detection of tumor-bearing tissues in different groups. **p < 0.01. Student t-test was used for comparison between groups.

Figure 8: Immunohistochemical analysis of the expression levels of ANXA8 and ki-67 in tumor-bearing tissues of different groups, scale bar was 100 μm.
This study investigated the expression patterns of human ANX family members ANXA1–11 and ANXA13 in cervical cancer by using data obtained from TCGA. We observed that ANXA8 exhibited significantly elevated expression levels in cervical cancer tissues. The results of clinical sample detection exhibited that ANXA8 was markedly upregulated in cervical cancer tissues and correlated with the metastasis stage of patients’ lymph nodes, FIGO stage, degree of differentiation, and depth of invasion. Cell-function and in vivo experiments showed that ANXA8 knockdown can significantly inhibit the colony formation, propagation, invasion, and migration of cervical cancer cells and inhibited the expression of Ki-67.
Research has shown that ANXs comprise a Ca2+-dependent phospholipid-binding protein superfamily. Their main functions are related to membrane transport and surface interactions, including but not limited to vesicle transport, cell proliferation, cell differentiation, signal transduction, and cell apoptosis (Koerdt et al., 2019). As demonstrated in vitro and in vivo, downregulated ANXA4 expression inhibited liver cancer cell proliferation and tumorigenesis, a possible key factor affecting liver carcinogenesis. Ikaros is an attractive ANXA4 inhibitor that may play an anticancer role in liver cancer (Senga and Grose, 2021). ANXA6 also inhibits the tumorigenesis of cervical cancer through autophagy induction (Sun et al., 2020). ANXA7 upregulates the expression of CDC5L, a critical cell-cycle regulator, thereby contributing to enhanced cell cycle progression, proliferation, and cell adhesion-mediated drug resistance in different myeloma cells (Liu et al., 2020). Accordingly, we speculated that the expression and molecular mechanism of different ANXA types in different tumor tissues also varied. Thus, elucidating the expression of the specific ANXA molecules in tumor tissues and the molecular mechanism of regulation increases the importance of this gene. The understanding and theoretical basis of assessments are of great significance. Studies have found that ANXA8 is involved in regulating the main signaling pathway between Ca2+ signal transduction and Ca2+-regulated cell-membrane dynamics in all eukaryotes, which are intimately correlated with the onset and progression of numerous diseases (Zhu et al., 2020). For instance, the level of ANXA8 mRNA in endometrial cells significantly increases. Cell experiments have confirmed that ANXA8 enhances endometrial-cell proliferation by activating the target protein kinase B (Akt) protein phosphorylation pathway, revealing the role of ANXA8 in the endometrium (Jiang et al., 2019). ANXA8 mRNA is also significantly found in ovarian cancer. With the progression of FIGO staging, the expression level of ANXA8 mRNA is substantially upregulated and is closely correlated with the overall survival and disease-free survival of patients diagnosed with ovarian serous tumors. An important potential indicator of survival and prognosis (Gou et al., 2019). In the current study, analysis of the TCGA database demonstrated that ANXA1, ANXA2, ANXA3, and ANXA8, members of the ANX family, are highly expressed in cervical cancer. The examination of more clinical samples revealed that ANXA8 expression was the most significant. Therefore, ANXA8 was selected for further investigations. IHC findings exhibited that ANXA8 was markedly upregulated in cervical cancer tissue and correlated with lymph-node metastasis, FIGO stage, degree of differentiation, and depth of invasion. This showed the association of ANXA8 with tumor differentiation, proliferation, metastasis, and invasion in cervical cancer patients, and the specific mechanism requires further investigations. ANXA8 can be used as a potential biological target or marker for cervical cancer diagnosis. Thus, determination of ANXA8 expression combined with smear or imaging can significantly improve the diagnosis rate of cervical cancer (Halim et al., 2021). Notably, cervical cancer is by far the most common human papillomavirus (HPV)-related disease, so further studies are needed to investigate whether ANXA8 is associated with HPV infection (Sundaram et al., 2021).
Tumor-cell proliferation and invasion trigger tumor development and metastasis; hence, studying the molecular mechanism of tumor cell proliferation and invasion has immense clinical significance (Senga and Grose, 2021). For example, in the carcinoma of oral squamous cells, ANXA8 expression is exclusively expressed in lymph-node metastasis, whereas normal lymph nodes do not exhibit such expression. ANXA8 mRNA expression was observed in all metastatic lymph nodes that tested negative for the keratin 19 (krt19) gene. ANXA8 and KRT19 mRNA may be effective biomarkers for the detection of lymph-node metastasis in patients with oral cavity squamous cell carcinoma (Oka et al., 2016). In gastric cancer, ANXA8 expression in tumor tissue was found to be increased, and the high upregulation of ANXA8 was closely linked to TNM stage and differentiation degree. Kaplan–Meier and COX proportional hazards analysis revealed that the upregulated expression of ANXA8 was closely linked with overall survival and disease-free survival. These findings suggested that ANXA8 may act as an oncogene for the formation of gastric cancer and as a therapeutic strategy for gastric cancer potential prognostic biomarkers (Ma et al., 2020). The outcomes of our cell-function experiments showed that knocking down ANXA8 significantly suppressed the colony formation, proliferation, invasion, and migration of cervical cancer cells. Results of in vivo experiments indicated that ANXA8 knockdown markedly suppressed the propagation of cervical cancer cells in nude mice and inhibited the expression of Ki-67. Previous studies have shown that a three-dimensional (3D) cell culture is a fundamental platform for drug discovery and the development of treatment for many diseases, including cervical cancer. In future work, we will use 3D spheroid tumor culture to explore the function of ANXA8 (Muniandy et al., 2021). Research has also demonstrated that ANXA8 can regulate the proliferation of human non-small lung cancer cells via the EGFR-AKT-mTOR signaling pathway (Zhou et al., 2021). LncRNA-TUG1/miR-140-3p regulates ANXA8 expression and promotes bladder cancer progression and metastasis (Yuan et al., 2021). Exosomal Lnc TUG1 derived from bone-marrow mesenchymal stem cells was found to promote bone-fracture recovery by regulating the miR-22-5p/ANXA8 axis (Li et al., 2023). Our experimental results showed as well that ANXA8 was an important functional molecule in a class of cells, which can significantly regulate various physiological functions of tumor cells.
In summary, the present study examined the expression of the ANXA8 gene as a targeted biomarker for evaluating the early diagnosis or postoperative of cervical cancer. It can serve as a new target and theoretical basis for subsequent studies on targeted drugs for cervical cancer treatment. The present study still has certain limitations. Despite investigating the impact of ANXA8 on cellular behavior, there is a lack of further molecular mechanistic explanations. Additionally, the findings of this study have not been validated through clinical trials. In future research, a more comprehensive investigation of the mechanistic role of ANXA8 in cervical cancer is necessary, along with an increase in sample size for clinical validation to explore the clinical significance of ANXA8.
Acknowledgement: We would like to thank the patients and their families and all the investigators, including the physicians, nurses, and laboratory technicians in this study.
Funding Statement: This work was supported by the project in Nantong Health and Family Planning Commission (MS2022045).
Author Contributions: WLZ, YL, and WPZ performed acquisition, analysis, and interpretation of data. YL and AQH drafted the manuscript. CZ, QH, and YZ provided technical and material support. WLZ and WPZ conducted design and supervision.
Availability of Data and Materials: All data in this study are available upon request by writing to the corresponding author.
Ethics Approval: This study was approved by the Ethics Committee of the Affiliated Tumor Hospital of Nantong University (2023-A09) and was conducted in accordance with relevant guidelines and regulations. Written informed consent was obtained from each participant.
Conflicts of Interest: The authors declare that they have no competing interests.
References
Araújo TG, Mota STS, Ferreira HSV, Ribeiro MA, Goulart LR, Vecchi L (2021). Annexin A1 as a regulator of immune response in cancer. Cells 10: 2245. [Google Scholar]
Bai LP, Chen YL, Zheng A (2022). Pharmacological targeting transient receptor potential canonical channel 6 modulates biological behaviors for cervical cancer HeLa and SiHA cell. Cancer Cell International 22: 145. [Google Scholar] [PubMed]
Bogani G, di Donato V, Scambia G, Raspagliesi F, Chiantera V et al. (2022). Radical hysterectomy for early stage cervical cancer. International Journal of Environmental Research and Public Health 19: 11641. [Google Scholar] [PubMed]
Christensen MV, Høgdall CK, Jochumsen KM, Høgdall EVS (2018). Annexin A2 and cancer: A systematic review. International Journal of Oncology 52: 5–18. [Google Scholar] [PubMed]
Enrich C, Rentero C, Meneses-Salas E, Tebar F, Grewal T (2017). Annexins: Ca2+ effectors determining membrane trafficking in the late endocytic compartment. Advances in Experimental Medicine and Biology 981: 351–385. https://doi.org/10.1007/978-3-319-55858-5 [Google Scholar] [CrossRef]
Gou R, Zhu L, Zheng M, Guo Q, Hu Y, Li X, Liu J, Lin B (2019). Annexin A8 can serve as potential prognostic biomarker and therapeutic target for ovarian cancer: Based on the comprehensive analysis of Annexins. Journal of Translational Medicine 17: 275. [Google Scholar] [PubMed]
Guo C, Liu S, Sun MZ (2013). Potential role of Anxa1 in cancer. Future Oncology 9: 1773–1793. [Google Scholar] [PubMed]
Halim A, Mustafa WA, Ahmad WKW, Rahim HA, Sakeran H (2021). Nucleus detection on pap smear images for cervical cancer diagnosis: A review analysis. Oncologie 23: 73–88. [Google Scholar]
Han PF, Che XD, Li HZ, Gao YY, Wei XC, Li PC (2020). Annexin A1 involved in the regulation of inflammation and cell signaling pathways. Chinese Journal of Traumatology 23: 96–101. [Google Scholar] [PubMed]
Heitzig N, Brinkmann BF, Koerdt SN, Rosso G, Shahin V, Rescher U (2017). Annexin A8 promotes VEGF-A driven endothelial cell sprouting. Cell Adhesion & Migration 11: 275–287. [Google Scholar]
Huang J, Bai X, Xie X, Chen L, Lan X, Zhang Q, Song L, Hong P, Du C (2022). A real-world study on oral vinorelbine for the treatment of metastatic breast cancer. Oncologie 24: 131–145. [Google Scholar]
Jiang X, Xue S, Kang T, Liu H, Ren H, Hua R, Ni D, Lei M (2019). Annexin A8 (ANXA8) regulates proliferation of porcine endometrial cells via Akt signalling pathway. Reproduction in Domestic Animals 54: 3–10. [Google Scholar] [PubMed]
Johnson CA, James D, Marzan A, Armaos M (2019). Cervical cancer: An overview of pathophysiology and management. Seminars in Oncology Nursing 35: 166–174. [Google Scholar] [PubMed]
Koerdt SN, Ashraf APK, Gerke V (2019). Annexins and plasma membrane repair. Current Topics in Membranes 84: 43–65. [Google Scholar] [PubMed]
Lauritzen SP, Boye TL, Nylandsted J (2015). Annexins are instrumental for efficient plasma membrane repair in cancer cells. Seminars in Cell & Developmental Biology 45: 32–38. [Google Scholar]
Li W, Li L, Cui R, Chen X, Hu H, Qiu Y (2023). Bone marrow mesenchymal stem cells derived exosomal Lnc TUG1 promotes bone fracture recovery via miR-22-5p/ANXA8 axis. Human Cell 36: 1041–1053. [Google Scholar] [PubMed]
Liu H, Guo D, Sha Y, Zhang C, Jiang Y, Hong L, Zhang J, Jiang Y, Lu L, Huang H (2020). ANXA7 promotes the cell cycle, proliferation and cell adhesion-mediated drug resistance of multiple myeloma cells by up-regulating CDC5L. Aging 12: 11100–11115. [Google Scholar] [PubMed]
Luan Y, Zhang W, Xie J, Mao J (2021). CDKN2A inhibits cell proliferation and invasion in cervical cancer through LDHA-mediated AKT/mTOR pathway. Clinical and Translational Oncology 23: 222–228. [Google Scholar] [PubMed]
Ma F, Li X, Fang H, Jin Y, Sun Q, Li X (2020). Prognostic value of ANXA8 in gastric carcinoma. Journal of Cancer 11: 3551–3558. [Google Scholar] [PubMed]
Méndez-Barbero N, Gutiérrez-Muñoz C, Blázquez-Serra R, Martín-Ventura JL, Blanco-Colio LM (2021). Annexins: Involvement in cholesterol homeostasis, inflammatory response and atherosclerosis. Clinical Investigation in Arteriosclerosis 33: 206–216. [Google Scholar]
Miller EA, Pinsky PF (2022). Cervical cancer screening and predictors of screening by diabetes status. Cancer Causes Control 33: 1305–1312. [Google Scholar] [PubMed]
Muniandy K, Ahmad ZA, Dass SA, Shamsuddin S, Kumaran NM, Balakrishnan V (2021). Growth and invasion of 3D spheroid tumor of HeLa and CasKi cervical cancer cells. Oncologie 23: 279–291. https://doi.org/10.32604/Oncologie.2021.015969 [Google Scholar] [PubMed] [CrossRef]
Oka R, Nakashiro K, Goda H, Iwamoto K, Tokuzen N, Hamakawa H (2016). Annexin A8 is a novel molecular marker for detecting lymph node metastasis in oral squamous cell carcinoma. Oncotarget 7: 4882–4889. https://doi.org/10.18632/oncotarget.6639 [Google Scholar] [PubMed] [CrossRef]
Popa SJ, Stewart SE, Moreau K (2018). Unconventional secretion of ANXs and galectins. Seminars in Cell & Developmental Biology 83: 42–50. [Google Scholar]
Rahangdale L, Mungo C, O’Connor S, Chibwesha CJ, Brewer NT (2022). Human papillomavirus vaccination and cervical cancer risk. British Medical Journal 379: e070115. [Google Scholar] [PubMed]
Ruan X, Jiang J (2022). RACGAP1 promotes proliferation and cell cycle progression by regulating CDC25C in cervical cancer cells. Tissue & Cell 76: 101804. [Google Scholar]
Schloer S, Pajonczyk D, Rescher U (2018). Annexins in translational research: Hidden treasures to be found. International Journal of Molecular Sciences 19: 1781. [Google Scholar] [PubMed]
Senga SS, Grose RP (2021). Hallmarks of cancer-the new testament. Open Biology 11: 200358. [Google Scholar] [PubMed]
Sun X, Shu Y, Xu M, Jiang J, Wang L, Wang J, Huang D, Zhang J (2020). ANXA6 suppresses the tumorigenesis of cervical cancer through autophagy induction. Clinical and Translational Medicine 10: e208. [Google Scholar] [PubMed]
Sundaram MK, Almutary AG, Haque S, F. SM, Hussain A (2021). Awareness of human papilloma virus and its association with cervical cancer among female university students: A study from United Arab Emirates. Oncologie 23: 269–277. [Google Scholar]
Xia C, Dong X, Li H, Cao M, Sun D et al. (2022). Cancer statistics in China and United States, 2022: Profiles, trends, and determinants. Chinese Medical Journal 135: 584–590. [Google Scholar] [PubMed]
Yuan JB, Gu L, Chen L, Yin Y, Fan BY (2021). Annexin A8 regulated by lncRNA-TUG1/miR-140-3p axis promotes bladder cancer progression and metastasis. Molecular Therapy Oncology 22: 36–51. [Google Scholar]
Zhou GZ, Sun YH, Shi YY, Zhang Q, Zhang L, Cui LQ, Sun GC (2021). [ANXA8 regulates proliferation of human non-small lung cancer cells A549 via EGFR-AKT-mTOR signaling pathway]. Molekuliarnaia Biologiia (Mosk) 55: 870–880. [Google Scholar]
Zhu L, Gou R, Guo Q, Wang J, Liu Q, Lin B (2020). High expression and potential synergy of human epididymis protein 4 and Annexin A8 promote progression and predict poor prognosis in epithelial ovarian cancer. American Journal of Translational Research 12: 4017–4030. [Google Scholar] [PubMed]
Supplementary Materials

Figure S1: No significant changes compared with adjacent tissues (normal tissues) were observed. CESC, cervical squamous cell carcinoma, and endocervical adenocarcinoma; T, tumor; N, normal.

Figure S2: Low expression of ANXA6 in cervical cancer. CESC, cervical squamous cell carcinoma, and endocervical adenocarcinoma T, tumor, N, normal, *p < 0.05.
Cite This Article
Copyright © 2023 The Author(s). Published by Tech Science Press.This work is licensed under a Creative Commons Attribution 4.0 International License , which permits unrestricted use, distribution, and reproduction in any medium, provided the original work is properly cited.


Submit a Paper
Propose a Special lssue
View Full Text
Download PDF
Downloads
Citation Tools